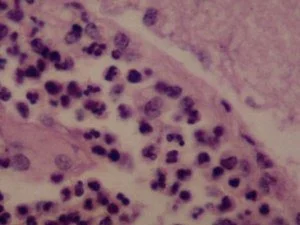

In Mexico, New Agers hope Dec. 21 brings new era

|
| A
Mayan dancer performs at the Xcaret Eco Theme Park on the outskirts of
Playa del Carmen, Mexico, Wednesday, Dec. 19, 2012. Amid a worldwide
frenzy of advertisers and new-agers preparing for a Maya apocalypse, one
group is approaching Dec. 21 with calm and equanimity, the people whose
ancestors supposedly made the prediction in the first place. |
MERIDA, Mexico (AP) -- Doomsday hour is here, at least in much of the world, and so still are we.
According to legend, the ancient Mayans' long-count calendar ends at midnight Thursday, ushering in the end of the world.
Didn't happen.
"This
is not the end of the world. This is the beginning of the new world,"
Star Johnsen-Moser, an American seer, said at a gathering of hundreds of
spiritualists at a convention center in the Yucatan city of Merida, an
hour and a half from the Mayan ruins at Chichen Itza.
"It is most important that we hold a positive, beautiful reality for ourselves and our planet. ... Fear is out of place."
As the appointed time came and went in several parts of the world, there was no sign of the apocalypse.
Indeed,
the social network Imgur posted photos of clocks turning midnight in
the Asia-Pacific region with messages such as: "The world has not ended.
Sincerely, New Zealand."
In Merida, the
celebration of the cosmic dawn opened inauspiciously, with a fumbling of
the sacred fire meant to honor the calendar's conclusion.
Gabriel
Lemus, the white-haired guardian of the flame, burned his finger on the
kindling and later had to scoop up a burning log that fell from the
ceremonial brazier onto the stage.
Still,
Lemus was convinced that it was a good start, as he was joined by about
1,000 other shamans, seers, stargazers, crystal enthusiasts, yogis,
sufis and swamis.
"It is a cosmic dawn," Lemus
declared. "We will recover the ability to communicate telepathically
and levitate objects ... like our ancestors did."
Celebrants later held their arms in the air in a salute to the Thursday morning sun.
"The
galactic bridge has been established," intoned spiritual leader Alberto
Arribalzaga. "At this moment, spirals of light are entering the center
of your head ... generating powerful vortexes that cover the planet."
Despite
all the ritual and banter, few here actually believed the world would
end Friday; the summit was scheduled to run through Sunday. Instead,
participants said they were here to celebrate the birth of a new age.
A
Mexican Indian seer who calls himself Ac Tah, and who has traveled
around Mexico erecting small pyramids he calls "neurological circuits,"
said he holds high hopes for Friday.
"We are preparing ourselves to receive a huge magnetic field straight from the center of the galaxy," he said.
Terry
Kvasnik, 32, a stunt man from Manchester, England, said his motto for
the day was "be in love, don't be in fear." As to which ceremony he
would attend on Friday, he said with a smile, "I'm going to be in the
happiest place I can."
At dozens of booths set
up in the convention hall, visitors could have their auras photographed
with "Chi" light, get a shamanic cleansing or buy sandals, herbs and
whole-grain baked goods. Cleansing usually involves having copal incense
waved around one's body.
Visitors could also
learn the art of "healing drumming" with a Mexican Otomi Indian master,
Dabadi Thaayroyadi, who said his slender hand-held drums are made with
prayers embedded inside. The drums emit "an intelligent energy" that can
heal emotional, physical and social ailments, he said.
During
the opening ceremony, participants chanted mantras to the blazing
Yucatan sun, which quickly burned the fair-skinned crowd.
Violeta
Simarro, a secretary from Perpignan, France, taking shelter under an
awning, noted that the new age won't necessarily be easy.
"It
will be a little difficult at first, because the world will need a
complete `nettoyage' (cleansing), because there are so many bad things,"
she said.
Not all seers endorsed the
celebration. Mexico's self-styled "brujo mayor," or chief soothsayer,
Antonio Vazquez Alba, warned followers to stay away from gatherings on
Friday. "We have to beware of mass psychosis" that could lead to
stampedes or "mass suicides, of the kind we've seen before," he said.
"If
you get 1,000 people in one spot and somebody yells `Fire!' watch out,"
Vazquez Alba said. "The best thing is to stay at home, at work, in
school, and at some point do a relaxation exercise."
Others saw the gathering as a model for the coming age.
Participants
from Asian, North American, South American and European shamanistic
traditions mingled amiably with the Mexican hosts.
"This
is the beginning of a change in priorities and perceptions. We are all
one," said Esther Romo, a Mexico City businesswoman who works in art
promotion and galleries. "No limits, no boundaries, no nationalities,
just fusion."
Gabriel Romero, a Los-Angeles
based practitioner of crystal skull channeling, was so sure it wasn't
the end of the world that he planned a welcome ceremony for the new age
at dawn on Saturday, when he would erect a stele, a stone monument used
by the Mayans to commemorate important dates or events.
The
Maya, who invented an amazingly accurate calendar almost 2,000 years
ago, measured time in 394-year periods known as baktuns. Some
anthropologists believe the 13th baktun ends Dec. 21. Still,
archaeologists have uncovered Mayan glyphs that refer to dates far, far
in the future, long beyond Dec. 21.
Yucatan
Gov. Rolando Zapata, whose state is home to Mexico's largest Mayan
population and has benefited from a boom in tourism, said he, too, felt
the good vibes.
"We believe that the beginning
of a new baktun means the beginning of a new era, and we're receiving
it with great optimism," Zapata said.
He said
thousands of tourists and spiritualists are expected for Friday's
once-in-5,125-years event. "All the flights to the city are completely
full," Zapata said.
The Yucatan state
government has even invited a scientist to speak about the Large Hadron
Collider in Switzerland, to debunk the idea it could produce
world-ending rogue particles, a concept popularized by author Steve
Alten in his recent book "Phobos, Mayan Fear."
Alten
suggests the rogue particles - "tiny black holes" - could unleash
earthquakes that might cause a huge tsunami, but acknowledges that
linking such events to Dec. 21 "is author's license."
"It's science fiction theory, I'm a science fiction writer," he told The Associated Press.
The
European Organization for Nuclear Research, however, has listed a
number of odd subatomic phenomena - "magnetic monopoles," "vacuum
bubbles" and "strangelets" - that could play a role in the next
apocalypse scare.
All of it amused Deyanira de
Alvarez, a tourist from Mexico City, as she snapped a photo of the
countdown clock mounted in the Merida international airport showing just
over two days left to "the galactic alignment."
"My
grandmother says that people have been talking about (the world ending)
ever since she was a little girl," De Alvarez said. "And look, grandma
is still here."